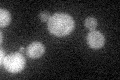
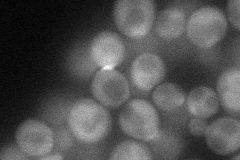
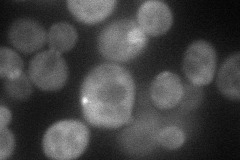
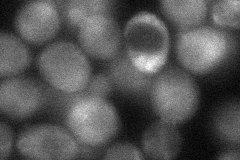
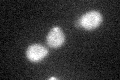

View description
Mitogen-activated protein (MAP) kinase kinase kinase acting in the protein kinase C signaling pathway, which controls cell integrity; upon activation by Pkc1p phosphorylates downstream kinases Mkk1p and Mkk2p
Localization:
Intensity:
Fold change:
Significance:
-
C’ GFP library in SD
cytosol21.34 -
N' NOP1pr-GFP in SD
bud neck55.6032 -
N' TEF2pr-mCherry in SD
bud neck52.1793 -
N' NATIVEpr-GFP in SD

below threshold16.0446 -
N' TEF2pr-VC and Cyto-VN in SD
cytosol,bud neck40.0852 -
C’ GFP library in SD+DTT
cytosol19.250.9No -
C’ GFP library in SD+H2O2

cytosol24.021.12No -
C’ GFP library in Starvation Media

cytosol18.520.86No -
C’ GFP library on the background of Pup2-DaMP

cytosol -
C’ GFP library on the background of CCT mutant

cytosol23.37021.09499No
